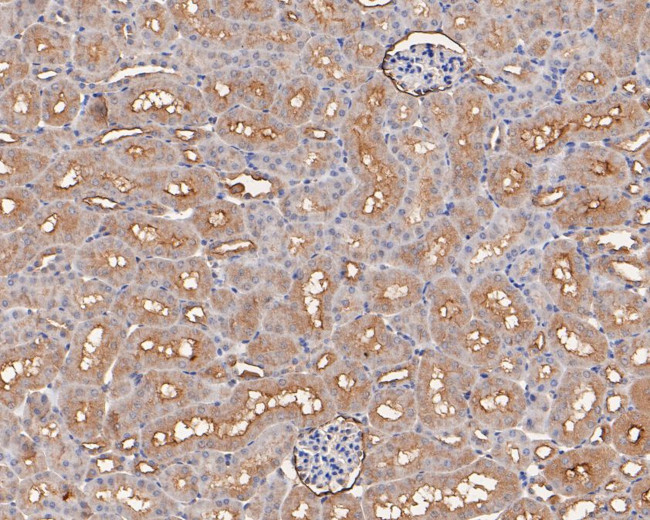
MCK10 Antibody in Immunohistochemistry (Paraffin) (IHC (P))

Search
Huabio
MCK10 Polyclonal Antibody
{{$productOrderCtrl.translations['antibody.pdp.commerceCard.promotion.promotions']}}
{{$productOrderCtrl.translations['antibody.pdp.commerceCard.promotion.viewpromo']}}
{{$productOrderCtrl.translations['antibody.pdp.commerceCard.promotion.promocode']}}: {{promo.promoCode}} {{promo.promoTitle}} {{promo.promoDescription}}. {{$productOrderCtrl.translations['antibody.pdp.commerceCard.promotion.learnmore']}}
图: 1 / 3
MCK10 Antibody (HA500141) in IHC (P)



产品信息
HA500141
种属反应
宿主/亚型
分类
类型
抗原
偶联物
形式
浓度
规格
纯化类型
保存液
内含物
保存条件
运输条件
靶标信息
DDR1 is a receptor tyrosine kinase activated by collagen and is reported to regulate adhesion, cell migration and other cellular processes. Receptor tyrosine kinases (RTKs) play a key role in the communication of cells with their microenvironment. These molecules are involved in the regulation of cell growth, differentiation and metabolism. The protein encoded by this gene is a RTK that is widely expressed in normal and transformed epithelial cells and is activated by various types of collagen. This protein belongs to a subfamily of tyrosine kinase receptors with a homology region to the Dictyostelium discoideum protein discoidin I in their extracellular domain. Its autophosphorylation is achieved by all collagens so far tested (type I to type VI). In situ studies and Northern-blot analysis showed that expression of this encoded protein is restricted to epithelial cells, particularly in the kidney, lung, gastrointestinal tract, and brain. In addition, this protein is significantly over-expressed in several human tumors from breast, ovarian, esophageal, and pediatric brain. This gene is located on chromosome 6p21.3 in proximity to several HLA class I genes. Alternative splicing of this gene results in multiple transcript variants.
仅用于科研。不用于诊断过程。未经明确授权不得转售。
篇参考文献 (0)
生物信息学
蛋白别名: CD167 antigen-like family member A; CD167a; Cell adhesion kinase; DAAP-278B20.1; DDR1d; discoidin domain receptor family, member 1; Discoidin receptor tyrosine kinase; Epithelial discoidin domain receptor 1; Epithelial discoidin domain-containing receptor 1; HGK2; juxtamembrane region; Mammary carcinoma kinase 10; MCK-10; neuroepithelial tyrosine kinase; neurotrophic tyrosine kinase receptor type 4; neurotrophic tyrosine kinase, receptor, type 4; protein-tyrosine kinase 3; Protein-tyrosine kinase 3A; Protein-tyrosine kinase MPK-6; protein-tyrosine kinase PTK-3; Protein-tyrosine kinase RTK-6; PTK3A protein tyrosine kinase 3A; TRK E; Tyrosine kinase DDR; Tyrosine-protein kinase CAK; unnamed protein product
基因别名: 6030432F18; AI323681; CAK; CD167; CD167a; DDR; DDR1; Drd1; EDDR1; HGK2; MCK10; Mpk6; NEP; NTRK4; PTK3; PTK3A; PTK3D; RTK6; TRKE
UniProt ID: (Human) Q08345, (Mouse) Q03146
Entrez Gene ID: (Human) 780, (Mouse) 12305, (Rat) 25678